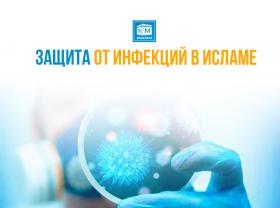

-
 Медицина Методы лечения Пророка Мухаммада с.а.с.
Медицина Методы лечения Пророка Мухаммада с.а.с.«Воистину, Аллах создал болезнь и (средства) исцеления. Так лечитесь же...
30 ноябрь 2024 2446 0 -
 Медицина СОМНИТЕЛЬНЫЕ ДОБАВКИ, СОДЕРЖАЩИЕСЯ В ЛЕКАРСТВАХ
Медицина СОМНИТЕЛЬНЫЕ ДОБАВКИ, СОДЕРЖАЩИЕСЯ В ЛЕКАРСТВАХНаша религия уделяет особое внимание здоровью человека. При выборе препаратов очень важ...
14 ноябрь 2024 2008 0 -
 Медицина Лечение по Сунне Пророка ﷺ - рецепты с хильбой
Медицина Лечение по Сунне Пророка ﷺ - рецепты с хильбойПророк Мухаммад ﷺ сказал: «Исцеляйте себя хильбой!». Хильбу у ра...
06 сентябрь 2024 2794 0 -
Медицина Защита от инфекций в Исламе
Медицина Защита от инфекций в ИсламеШирокое распространение инфекционных заболеваний всё чаще волнует работников здравоохра...
04 сентябрь 2024 1874 0 -
 Медицина Как сохранить здоровье в жару?
Медицина Как сохранить здоровье в жару?Солнечный удар возникает вследствие перегрева непокрытой головы лучами солнца. Происход...
22 июль 2024 1651 0 -
 Медицина Как ритуалы Ислама стимулируют мозг и защищают от негатива?
Медицина Как ритуалы Ислама стимулируют мозг и защищают от негатива?Чем дальше идут научные открытия, тем больше подтверждений несомненной пользы всего, чт...
18 июль 2024 1639 0 -
 Медицина Молитва, сон и здоровье человека
Медицина Молитва, сон и здоровье человекаВ конце напряжённого дня человек с нетерпением ждёт возможности поспать и восстановить ...
06 май 2024 1907 0 -
 Медицина Сколько раз можно есть в течение суток?
Медицина Сколько раз можно есть в течение суток?В хадисе Пророка ﷺ сказано: «Мы являемся тем народом, который принимает пищ...
18 апрель 2024 2689 0 -
 Медицина Апатия после зимы. Что делать?
Медицина Апатия после зимы. Что делать?Состояние безразличия ко всему, что происходит вокруг человека, мешает ему эффективно р...
04 апрель 2024 1938 0 -
 Медицина Что говорят Кур`ан и наука о боли?
Медицина Что говорят Кур`ан и наука о боли?В течение долгого времени люди полагали, что болевые ощущения возникают в мозге. И лишь...
27 февраль 2024 1841 0 -
 Медицина Предсказание Пророка ﷺ о проблеме ожирения
Медицина Предсказание Пророка ﷺ о проблеме ожиренияВ одном из хадисов, в котором описываются порицаемые дела людские времён, грядущих посл...
15 февраль 2024 2231 0 -
 Медицина Каким должен быть врач-мусульманин?
Медицина Каким должен быть врач-мусульманин?Врач – одна из наиболее древних и жизненно необходимых профессий. Ежедневно медик...
08 февраль 2024 2289 0 -
 Медицина Эти 5 советов Пророка ﷺ признал весь научный мир
Медицина Эти 5 советов Пророка ﷺ признал весь научный мирИслам является наилучшим из подарков, дарованных нам Господом, потому как соблюдение пр...
09 октябрь 2023 2059 0 -
 Медицина Чудеса сотворения: жир – это лишний элемент нашего организма?!
Медицина Чудеса сотворения: жир – это лишний элемент нашего организма?!Современный человек беспощадно пытается бороться с жировыми отложениями. Мучительные ди...
03 октябрь 2023 2147 0 -
 Медицина Лекарство от всех болезней, кроме смерти
Медицина Лекарство от всех болезней, кроме смертиМасло чёрного тмина получают из сырых семян растения методом холодного отжима. Использо...
06 сентябрь 2023 2087 0











